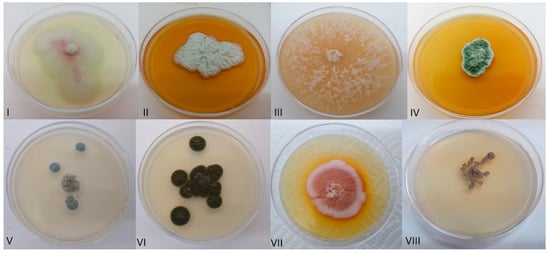

Simple Summary
The domesticated carmine cochineal produces pigments used in food, cosmetics, and the textile industry. Its use dates to the pre-Hispanic period and thus is an Amerindian legacy. Cochineals grow and feed on the edible leaves of cacti. Since insects feed on plant sap, they may obtain their microbes from the plants and indeed we found here that some of the fungi in the insect guts are the same as those encountered in cacti. Fungi may help in digestion as they are capable of breaking down plant polymers in cultures and inside guts. We found fungi inside cochineals during microscopic examinations using different procedures to detect fungi. One of the isolated fungi produces a purple pigment that resembles the carminic acid. This study identified several potential functions of cochineal fungi and examined their plant origin.
Abstract
The cochineal insect Dactylopius coccus Costa (Hemiptera) has cultural and economic value because it produces carminic acid that is used commercially. In this study, distinct fungi were cultured from dissected tissue and identified as Penicillium, Coniochaeta, Arthrinium, Cladosporium, Microascus, Aspergillus, and Periconia. Fungi were microscopically observed inside cochineals in the gut, fat body, and ovaries. Since cochineals spend their lives attached to cactus leaves and use the sap as feed, they can obtain fungi from cacti plants. Indeed, we obtained Penicillium, Aspergillus, and Cladosporium fungi from cacti that were identical to those inside cochineals, supporting their plant origin. Fungi could be responsible for the degrading activities in the insect guts, since cellulase, pectinase, and amylase enzymatic activities in insect guts decreased in fungicide-treated cochineals. Our findings set the basis for the further study of the interactions between insects, fungi, and their host plants.
1. Introduction
Fungi and insects are two of the most diverse groups of eukaryotes [1] and in insects, fungi may have a vast diversity of effects from obligate mutualisms to parasitism [2,3]. These associations have been studied in several insect groups such as ants [4], wasps [5], termites [6], leafhoppers [7], bees [8], and beetles [9]. The environmental success of insects has been linked to their beneficial associations with symbiotic microbes. Fungal symbionts may provide insects with vitamins, sterols, or enzymes to obtain sugars from plant polysaccharides [10,11]. Most hemipterans are plant-sucking insects; thus, with nutritional deficiencies in their diet, these insects would be prone to a dependency on microbial symbionts [12].
Fungal symbionts from some scale insects are known [13,14]. A comprehensive review of fungi in the soft scale insects from Hemiptera has been published, showing the fungi present in different species, their location within insects, and their possible transmission to offspring [15]. In many cases, fungi reside in the fat body or hemolymph and have thick cell walls. It is remarkable that fungi have substituted bacterial symbionts in a few cases. Seemingly, in Hemiptera, fungal symbioses are less common in Sternorrhyncha compared to Auchenorrhyncha [15]. Seven Coccidae species from the Mediterranean area [16] and 28 species from Southern China [17], which feed on plant sap, contained members of the Ophiocordyceps-allied fungi. The presence of Ophiocordyceps in different developmental stages of soft scale insects was explored, finding that it predominated in the first and second instar nymphs [17]. Ophiocordyceps are considered the primary symbionts because they were found in all tested insects and in eggs [16]. In contrast, yeast-like symbionts were observed in the cytoplasm of fat body cells but not in eggs of Kermes quercus from the coccoid family Kermesidae [18]. However, in the mango mealybug Rastrococcus iceryoides (Coccoidea: Pseudococcidae), a transovarial transmission of yeast-like symbionts was suggested [18].
The carmine cochineal insect Dactylopius coccus (Costa, 1835) is a hemipteran that belongs to the superfamily Coccoidea and the family Dactylopiidae. It originated in Oaxaca, Mexico [13] and feeds on Opuntia cacti, mostly Opuntia ficus-indica (Mill, 1768), to which females remain attached for most of their life cycle. D. coccus shows extreme sexual dimorphism; adult males are several times smaller in size, winged, and have a short lifespan of only a few days. D. coccus is one of the few domesticated insects in Mexico and has been cultivated since pre-Hispanic times because of its carminic acid, a red pigment that changes color depending on pH. Carmine is used in the cosmetic, food, and textile industries [19]. In 2019, Bustamante-Brito et al. [20] found evidence of nitrogen fixation in D. coccus by the betaproteobacteria Candidatus Dactylopiibacterium carminicum, which may provide vitamins and amino acids to the insect. Spiroplasma and Wolbachia may be found as well inside cochineals [21,22].
In the Dactylopiidae family, Cryptococcus has been isolated from D. opuntiae (Cockerell, 1896) D. confusus, and D. coccus, whereas Rhodotorula has been isolated from D. confusus and D. coccus, Trametes from D. opuntiae, Debaryomyces from D. confusus, and Phanerochaete, Irpex, Stereum, Periconia, and Penicillium have only been described in D. coccus [23]. The functional roles of most fungal symbionts from scale insects remain unknown. A previous report on a fungal community associated with D. coccus described the role of Cryptococcus in uric acid catabolism in the cochineal [22]. The microbial digestion of plant polysaccharides is required since insects lack the enzymes to hydrolyze the cellulose, hemicellulose, pectin, and lignin commonly found in plant diets [24,25]. Penicillium, Cladosporium, and Aspergillus are known to be capable of producing pectinases, cellulases, and xylanases [26]. In termites that feed on wood, fungi contribute to plant polysaccharide degradation [27], but in Coccoidea, specifically in Dactylopiidae, it is not known how complex sugars are catabolized.
The resident microorganisms of herbivores may have a plant [28] or a maternal origin [29]. This work aimed to define the possible origins of fungal symbionts in the cochineals and to explore some of the functional roles of fungal symbionts in D. coccus.
2. Materials and Methods
2.1. Sampling
Insects were donated by a farm in Tepoztlan, Morelos (18.990441, −99.117425) that harvests cochineals for carmine production. Only adult females were used in this study. Insects were sampled with the cacti they were attached to since they cannot survive without them.
2.2. Fungal Isolation from Dactylopius coccus Tissues and Cultures
For fungal isolation, 30 adult females were detached from different cacti and rinsed with 100% and 70% ethanol and sterile water twice for 1 min each to remove the external wax and dust. They were then dissected under sterile conditions; the cuticle was removed, and internal organs (whole gut, ovaries, and fat body) were placed in 1 mL of PBS buffer. Immediately, the tissue was homogenized in a mortar, then inoculated in PDA (Potato Dextrose Agar: 200 g of potato per liter, 20 g dextrose, 20 g agar), ME (Malt Extract: 20 g malt extract and 20 g agar), PY (Peptone Yeast: 20 g peptone, 10 g dextrose, 10 g yeast extract, and 20 g agar), and YPD (Yeast Peptone Dextrose: 20 g dextrose, 10 g peptone, 5 g yeast extract, and 20 g agar) culture plates at three dilutions (100, 10−1, and 10−2). Petri dishes were inoculated using beads and incubated at 28 °C for 22 days. Fungal colonies were subcultured in the corresponding medium and then stored in a liquid medium with 30% glycerol at −70 °C.
We tested different growth conditions for Coniochaeta sp: two oxygen concentrations (microaerobic and aerobic); YPD and a medium with 40% filtered insect extract; and three different agar concentrations (0.5%, 1%, and 1.5%) at two different temperatures (28 °C and 37 °C). We incubated for 72 h and then applied lactophenol blue to a sample from each condition to visualize the predominant cellular type with a Leica microscope with LAS DFC295 software, at 20 and 40×.
2.3. Light and Transmission Electron Microscopy (TEM) of D. coccus Tissue
Dissected insect tissue from the gut, ovaries, and fat body were used for light and TEM. The tissues were treated with lactophenol blue for light microscopy to stain the fungal cell walls [30]. Calcofluor white was used to detect the chitin [31] and DAPI for visualizing nuclei. For TEM, the fixing solution was added to the insect with the first incision of the dissection procedure and the tissue was fixed with 2% glutaraldehyde for 2 h and 1% osmium tetroxide for 1 h and dehydrated with ethanol. Then, we added propylene oxide and embedded it in LR white resin. Grids were stained with 4% uranyl acetate and 1% lead citrate. We used a Leica microscope with LAS DFC295 software for light microscopy and a Carl Zeiss, Germany LIBRA 120transmission electron microscope.
2.4. Fungal Identification
Fungal DNA was obtained from liquid cultures using the Quick-DNA fungal/bacterial miniprep kit by Zymo Research according to the kit protocol. DNA was PCR amplified with ITS1-2 and ITS2 primers, as described [23]. PCR products were sequenced at Macrogen Inc. (Seoul, Republic of Korea) Sequences were uploaded at GenBank with the accession numbers: PP724723-PP724743.
The microscopic fungal structures were observed from 14-day microcultures stained with lactophenol blue with an optical microscope at 40 and 60×. For morphological identification, we used taxonomy guides for fungi [32].
ERIC-PCR patterns were obtained from fungal DNA using ERIC primers [33]. Bands were visualized in agarose gels.
2.5. Fungal Isolation from Cacti
To determine if cochineal fungi originated from the cacti on which cochineals feed, we obtained fungal isolates from the cactus leaves used for insect propagation. Cactus leaves were superficially disinfected twice with ethanol at 100% and 70% and then the cuticle was removed under sterile conditions. One cm3 of the internal cacti tissue was placed on individual agar plates with the same media to isolate fungi from the cochineals. We also homogenized the inner tissues, prepared three dilutions (100, 10−1, and 10−2), and dispersed them in culture plates with glass beads. We incubated the plates at 28 °C for 22 days.
2.6. Plant-Polysaccharide Degradation in the Cochineal Intestines
Protein gut extracts were obtained from 90 adult female insects, which were dissected, and their intestines homogenized by mechanical disruption. The intestinal tissue particles were separated by centrifugation at 16,000 rpm, and the supernatant was resuspended in a PBS solution with a protease inhibitor (Roche) and sterilized by microfiltration.
The presence of enzymatic activities, including cellulases, amylases, and pectinases, was determined using the dinitrosalicylic acid (DNS) assay to quantify the reducing sugars. To determine the enzymatic activities, 30 µL of gut extract was incubated with each substrate at 2% in 0.1 M phosphate buffer (pH 8). Each reaction was incubated at 28 °C for 24 h, and 50 µL of DNS was added. The reactions were incubated in boiling water for 5 min and transferred to ice for 5 min. Distilled water (0.5 mL) was added, and the absorbance was read at 540 nm using the 0 h time point as a blank. A standard glucose curve (0–2 g/L) was used to calculate the reducing sugar content. With glucose as the standard, we obtained a correlation coefficient of 0.99.
Additionally, we detected simple sugars in the protein gut extract with thin-layer chromatography (TLC) and after incubation with each substrate at 2% for 5 min and 3 h at 30 °C. Glucose and galacturonic acid standards indicated cellulose, starch, and pectin degradation. We placed 20 µL of the gut extract on a silica gel aluminum-backed plate (Merck, Rahway, NJ, USA) and eluted twice with butanol:acetic acid: water (60:30:30 v/v/v) for 12 h, drying between cycles. It was then developed with alpha-naphthol at 100 °C for 2–3 min.
2.7. In Planta Fungicide Treatment of Cochineals
We used fludioxonil (Sigma, St. Louis, MA, USA) at 50 µL/mL (180 µM) in 20 µL injections every 5 cm2 of the cactus leaf surface. Daily application was performed for seven consecutive days. After treatment, the cochineals did not look damaged and were similar to the control cochineals. We performed the DNS assay to detect polysaccharide degrading activities in the guts of cochineals detached from cacti before and after the fungicide treatment.
2.8. Plant-Polysaccharide Degrading Capabilities of Fungal Isolates
For the in vitro qualitative assays, the fungi were placed directly on petri dishes with agar containing each substrate: cellulose 2 g/L, starch 20 g/L, and pectin 20 g/L. Plates were incubated for 24–72 h. Cellulose degrading activity was visualized by adding Congo red 0.02%. Amylase activity was revealed using Lugol (iodine 1% and potassium iodide 2%), and pectinase activity was detected with CTAB (cetyl trimethyl ammonium bromide) 5%. Fungal growth and halos were measured in centimeters and ratios were used as arbitrary units to compare among isolates
3. Results
3.1. Fungal Isolates from Cochineals
We sampled only adult female cochineals and not different developmental stages. We obtained 20 morphologically different isolates (Table 1) (Figure 1) from the gut, ovaries, and fat body, corresponding to 12 fungal species (according to the ITS sequence), all belonging to the Ascomycota phylum in six orders: Eurotiales (45% of all isolates), Pleosporales (5%), Microascales (5%), Coniochaetales (5%), Xylariales (10%), and Capnodiales (30%).

Table 1.
Dactylopius coccus fungal isolates and enzymatic activities.
Figure 1.
Fungal isolates culture plates belonging to (I) Periconia sp., (II) Aspergillius hiratsukae, (III) Arthrinium gutiae, (IV) Penicillium brevicompactum, (V) Penicillium olsonii, (VI) Cladosporium cladosporioides, (VII) Coniochaeta sp., and (VII) Microascus verrucosus.
3.2. Fungi inside the Cochineal
We observed some hyphae-like structures in the gut, fat body, and ovaries with light microscopy with blue lactophenol, calcofluor white, and nigrosine staining, and we also found these structures to be DNA-dense with DAPI fluorescence (Figure 2).

Figure 2.
Micrographs of Dactylopius coccus tissues: gut, fat body, and ovary, stained with lactophenol blue, calcofluor white, nigrosin, and DAPI, showing hyphae-like structures (indicated with arrows).
3.3. Fungal Isolates from Cacti
From cactus leaves, we obtained 38 fungal isolates (Supplementary Table S1) (PP892009-PP892046) belonging to eight genera; Alternaria, Cladosporium, Purpureocillium, Penicillium, Aspergillus, Mucor, Keithomyces, and Cordyceps, three of which are also present in D. coccus (Cladosporium, Penicillium, and Aspergillus). A phylogenetic tree of fungal isolates from the cacti and the insect showed that some Penicillium isolates from the insect and the cacti were genetically similar (Figure 3). Furthermore, Penicillium brevicompactum isolates from cacti and cochineals had identical PCR patterns obtained with ERIC primers (Figure 3). ERIC-PCR fingerprinting has been used in fungal diversity studies [34].

Figure 3.
(A) ERIC-PCR patterns of Penicillium isolates from Dactylopius coccus (PbD and PoD) and Opuntia (PbO). (1) 1 Kb marker, (2) P. brevicompactum PDAC0H1, (3) P. brevicompactum PDAG-1H1, (4) P. brevicompactum PDAG0H2 from D. coccus, (5) Penicillium olsonni PDAO-1H1 from D. coccus, (6) P. brevicompactum 31N, (7) P. brevicompactum 9N from Opuntia plants. (B) Molecular phylogeny of fungal ITS1-2 with Maximum Likelihood and Kimura 2-parameter model with 1,000 bootstraps.
3.4. Enzymes for Plant–Polysaccharide Degradation in the Intestines and a Fungicide Treatment in Opuntia Leaves Infected with Cochineals
We found cellulase, pectinase, and amylase enzymatic activities in the cochineal gut extracts with the DNS method. Using thin-layer chromatography, we observed an increase in glucose and galacturonic acid after incubation with the gut extracts with cellulose, starch, and pectin confirming the presence of active enzymes in guts (Figure 4). The decreased activities (p < 0.5) after the fungicide treatment (Figure 5) were consistent with the hypothesis that associated fungi provide these enzymes in cochineal guts.

Figure 4.
Thin-layer chromatography of sugars produced by the gut extract after 5 min (SA) and 3 h (SB) incubation with starch, after 5 min (CA) and 3 h (CB) incubation with cellulose, and after 5 min (PA) and 3 h (PB) incubation with pectin, compared to gut extract without substrate (C). Glucose (G) and galacturonic acid (GA) were used as standards.

Figure 5.
Enzymatic activities of cellulase, pectinase, and amylase before (BT) and after (AT) treatment with fludioxonil fungicide according to DNS assay. Measurements provided as g/L of reducing sugars.
3.5. Plant-Polysaccharide Degrading Capabilities in Fungal Isolates
Substrates tested for degradation with fungal cultures in vitro were pectin, cellulose, and starch. We used guaiacol for laccases. The values of the ratio of the halo in culture plates, divided by the fungal colony size, in centimeters, were the arbitrary units to compare between isolates. All cochineal fungal isolates showed degrading activities (Table 1). All fungal isolates tested had cellulase activity and all but Arthrinium had pectinase activity. All but Periconia and Coniochaeta had amylase activity. It should be noted that distinct isolates within Cladosporium or Microascus did not show identical activities. Only Cladosporium (with few exceptions) had laccase activity. Laccases can degrade carminic acid.
3.6. Culture Conditions and Morphology of Coniochaeta
Coniochaeta is a dimorphic fungus (Figure 6) and we tested culture conditions that would drive the formation of yeast or hyphal cells. Yeast was predominant in a peptone-yeast medium in aerobic conditions. Coniochaeta grew at 37 °C but temperature did not affect the morphology, as observed in most pathogenic dimorphic fungi [35].

Figure 6.
Coniochaeta dimorphic morphology (A) yeast-like (B) filamentous form.
4. Discussion
4.1. On the Origin of Fungi in Cochineals
Insects are frequently colonized by fungal symbionts that may benefit the host [12,36,37]. From cochineal dissected guts we isolated distinct fungi belonging to Ascomycota. Some of the cochineal fungi encountered in their guts may be acquired directly from the cactus leaves where the cochineals grow and feed. Using ITS sequences, we identified Penicillium, Aspergillus, and Cladosporium fungi common to cacti and cochineals. Genomic fingerprints used to characterize bacteria and fungi strains [33] showed identical ERIC-PCR patterns in some Penicillium isolates from cacti and cochineals. Penicillium, Cladosporium, and Aspergillus were previously reported in cacti [38].
Besides being in guts, fungi may be encountered inside the cochineal. We detected them during microscopic examinations of the fat body, hemolymph, and ovaries, and the observed structures were detected with dyes used to reveal the fungi. Some of the fungi observed inside the cochineal showed similar fungal structures to those observed in fungal cultures. Insect-associated fungi have been reported in different insect tissues [39,40] in the form of yeast and yeast-like hyphae and spores [41], but there are no reports of hyphae in the ovaries as we found here, which led us to suggest that some fungi may be maternally transmitted besides being obtained from cacti.
4.2. Roles of Fungi in Cochineals
In carmine cochineals, we explored the role of fungi in digestion. Our results showed active plant-polymer degrading enzymes in the cochineal guts, which can help degrade the ingested polymers and transform them into assimilable forms. We found that fungi seemingly produced enzymes in the gut such as cellulases, amylases, and pectinases because fludioxonil-treated cochineals barely exhibited those activities in their guts. Fludioxonil was previously used with other fungicides such as ketoconazole and amphotericin B to test the role of fungi in urease production inside the cochineals [29]. Several studies highlight the importance of fungal communities in plant polymer degradation, i.e., the leaf-cutting ant has fungal gardens and fungal communities that are present in the mycetome of some beetles [39,42] or the case of the tortoise leaf beetles (Chrysomelidae: Cassidinae) and their obligate fungal symbiont Stammera, which is indispensable for the degradation of the pectin found in the beetle feed [43]. Our previously published results reveal that animals eat endophytic bacteria [44]. Remarkably, fungi from cacti may be ingested by humans because these cacti are edible, nutrient-rich, and may be eaten raw or juiced for human consumption. Some of these fungi produce mycotoxins [45]. In humans, gut bacteria are responsible for plant-fiber digestion [28], but the role of fungi in digestion has not been fully explored.
Using the cochineal fungal isolates, we detected enzymatic activities in cultures. Penicillium, Cladosporium, and Aspergillus are known to be capable of producing pectinases, cellulases, and xylanases [26]. Fungi are well appreciated in biotechnological applications for their efficient degradation of plant polymers [46,47], and cochineals profit from that.
Notably, from the fat body, we cultured Periconia fungal isolates that produced a purple pigment with visual similarities to carminic acid. Certainly, it is worth studying the chemical structure of the novel purple pigment produced by Periconia. There are no reports of Periconia-producing pigments. Penicillium, Coniochaeta, and Periconia are known to produce a wide diversity of metabolites and antibiotics [48,49,50], which could help control the cochineal microbial populations if produced inside the cochineal. Antibiotic production by these fungi deserves to be explored.
In culture, we obtained the dimorphic fungus Coniochaeta and tested conditions driving its morphological switch, finding that nutrient-rich media in aerobic conditions favor yeast over hyphal growth. Entomopathogenic dimorphic fungi change their cellular morphology from hyphae to yeast inside the insect hemocoel to escape the Toll immune pathway. This morphological switch is driven by nutrient and oxygen concentrations [51].
We found some fungi similar to those previously reported by Vera Ponce de Leon et al. [52], such as Periconia, Penicillium, Cladosporium, and Aspergillus, despite the collection sites being separated by kilometers and a time difference between the studies of a few years. Some of the common fungi encountered in both studies may constitute the core fungal community and perhaps the cochineal holobiont (complete organism) [53], together with the nitrogen-fixing Candidatus Dactylopiibacterium carminicum, which is a primary symbiont in wild and domesticated cochineals [54].
4.3. Perspectives
It has been reported that fungal symbionts in insects produce lipids including sterols [55,56]. In our laboratory, we are exploring whether cochineal fungi produce them. Moreover, since we found that some isolated fungi produce pigments, we have obtained the genome sequence of the Periconia sp. fungus and expect that its analysis will reveal the biosynthetic pathway for pigment production. In addition, as it is known that fungi such as Penicillium produce antibiotics, our fungal collection may be very valuable because it could be used to obtain novel antibiotics. All this would lead us to propose new strategies to assess the role of fungi in cochineal fitness and to explore the interactions of different fungi among themselves and with the resident bacteria.
Supplementary Materials
The following supporting information can be downloaded at: https://www.mdpi.com/article/10.3390/insects15100783/s1, Table S1: Opuntia fungal isolates.
Author Contributions
P.G.-R. planned and performed experiments, cultures, and sequence analysis, and prepared the original draft. D.H.-O. performed a DNS assay, participated in the writing and reviewing. R.B.-B. performed phylogenetic analyses. M.A.R. performed ERIC-PCR electrophoresis. E.M.-R. supervised, obtained funding, and participated in the writing and reviewing. All authors have read and agreed to the published version of the manuscript.
Funding
This research was funded by PAPIIT UNAM 206124.
Data Availability Statement
All relevant data can be found within the manuscript.
Acknowledgments
P.G.R. was a Ph.D. student from the Programa de Doctorado en Ciencias Biomédicas (PDCB), Universidad Nacional Autónoma de México (UNAM) and received fellowship 887176 from the Consejo Nacional de Humanidades, Ciencias y Tecnologías de México (CONAHCyT). We thank Julio Martínez-Romero and Mónica Rosenblueth for technical support and M. Dunn for reading the manuscript.
Conflicts of Interest
The authors declare no conflicts of interest.
References
- Hawksworth, D.L.; Lücking, R. Fungal diversity revisited: 2.2 to 3.8 Million Species. Microbiol. Spectr. 2017, 5. [Google Scholar] [CrossRef] [PubMed]
- Matsuura, Y.; Moriyama, M.; Łukasik, P.; Vanderpool, D.; Tanahashi, M.; Meng, X.Y.; McCutcheon, J.P.; Fukatsu, T. Recurrent symbiont recruitment from fungal parasites in cicadas. Proc. Natl. Acad. Sci. USA 2018, 115, E5970–E5979. [Google Scholar] [CrossRef] [PubMed]
- Sung, G.-H.; Poinar, G.O.; Spatafora, J.W. The oldest fossil evidence of animal parasitism by fungi supports a Cretaceous diversification of fungal-arthropod symbioses. Mol. Phylogenet. Evol. 2008, 49, 495–502. [Google Scholar] [CrossRef] [PubMed]
- Mueller, U.G.; Kardish, M.R.; Ishak, H.D.; Wright, A.M.; Solomon, S.E.; Bruschi, S.M.; Carlson, A.L.; Bacci, M., Jr. Phylogenetic patterns of ant–fungus associations indicate that farming strategies, not only a superior fungal cultivar, explain the ecological success of leafcutter ants. Mol. Ecol. 2018, 27, 2414–2434. [Google Scholar] [CrossRef]
- Fu, N.; Wang, M.; Wang, L.; Luo, Y.; Ren, L. Genome sequencing and analysis of the fungal symbiont of Sirex noctilio, Amylostereum areolatum: Revealing the biology of fungus-insect mutualism. Msphere 2020, 5, 10–1028. [Google Scholar] [CrossRef]
- Rouland, C.; Lenoir, F.; Lepage, M. The role of the symbiotic fungus in the digestive metabolism of several species of fungus-growing termites. Comp. Biochem. Physiology. A Comp. Physiol. 1991, 99, 657–663. [Google Scholar] [CrossRef]
- Sacchi, L.; Genchi, M.; Clementi, E.; Bigliardi, E.; Avanzati, A.; Pajoro, M.; Negri, I.; Marzorati, M.; Gonella, E.; Alma, A.; et al. Multiple symbiosis in the leafhopper Scaphoideus titanus (Hemiptera: Cicadellidae): Details of transovarial transmission of Cardinium sp. and yeast-like endosymbionts. Tissue Cell 2008, 40, 231–242. [Google Scholar] [CrossRef]
- Paludo, C.R.; Pishchany, G.; Andrade-Dominguez, A.; Silva-Junior, E.A.; Menezes, C.; Nascimento, F.S.; Currie, C.R.; Kolter, R.; Clardy, J.; Pupo, M.T. Microbial community modulates growth of symbiotic fungus required for stingless bee metamorphosis. PLoS ONE 2019, 14, e0219696. [Google Scholar] [CrossRef]
- Biedermann, P.H.; Klepzig, K.D.; Taborsky, M.; Six, D.L. Abundance and dynamics of filamentous fungi in the complex ambrosia gardens of the primitively eusocial beetle Xyleborinus saxesenii Ratzeburg (Coleoptera: Curculionidae, Scolytinae). FEMS Microbiol. Ecol. 2013, 83, 711–723. [Google Scholar] [CrossRef]
- Davis, T.S.; Stewart, J.E.; Mann, A.; Bradley, C.; Hofstetter, R.W. Evidence for multiple ecological roles of Leptographium abietinum, a symbiotic fungus associated with the North American spruce beetle. Fungal Ecol. 2019, 38, 62–70. [Google Scholar] [CrossRef]
- Henrik, H.D.F.L.; Schiøtt, M.; Rogowska-Wrzesinska, A.; Nygaard, S.; Roepstorff, P.; Boomsma, J.J. Laccase detoxification mediates the nutritional alliance between leaf-cutting ants and fungus-garden symbionts. Proc. Natl. Acad. Sci. USA 2013, 110, 583–587. [Google Scholar]
- Biedermann, P.H.; Vega, F.E. Ecology and evolution of insect–fungus mutualisms. Annu. Rev. Entomol. 2020, 65, 431–455. [Google Scholar] [CrossRef] [PubMed]
- Szklarzewicz, T.; Michalik, A.; Michalik, K. The Diversity of Symbiotic Systems in Scale Insects. In Symbiosis: Cellular, Molecular, Medical and Evolutionary Aspects; Kloc, M., Ed.; Springer: Berlin/Heidelberg, Germany, 2020; Volume 69, pp. 469–495. [Google Scholar] [CrossRef]
- Van Dam, A.R.; Portillo Martinez, L.; Chavez, A.J.; May, B.P. Range wide phylogeography of Dactylopius coccus (Hemiptera: Dactylopiidae). Ann. Entomol. Soc. Am. 2015, 108, 299–310. [Google Scholar] [CrossRef]
- Szklarzewicz, T.; Michalik, K.; Grzywacz, B.; Kalandyk-Kołodziejczyk, M.; Michalik, A. Fungal associates of soft scale insects (Coccomorpha: Coccidae). Cells 2021, 10, 1922. [Google Scholar] [CrossRef]
- Gomez-Polo, P.; Ballinger, M.J.; Lalzar, M.; Malik, A.; Ben-Dov, Y.; Mozes-Daube, N.; Perlman, S.J.; Iasur-Kruh, L.; Chiel, E. An exceptional family: Ophiocordyceps—Allied fungus dominates the microbiome of soft scale insects (Hemiptera: Sternorrhyncha: Coccidae). Mol. Ecol. 2017, 26, 5855–5868. [Google Scholar] [CrossRef]
- Deng, J.; Yu, Y.; Wang, X.; Liu, Q.; Huang, X. The ubiquity and development-related abundance dynamics of Ophiocordyceps fungi in soft scale insects. Microorganisms 2021, 9, 404. [Google Scholar] [CrossRef]
- Podsiadło, E.; Michalik, K.; Michalik, A.; Szklarzewicz, T. Yeast-like microorganisms in the scale insect Kermes quercus (Insecta, Hemiptera, Coccomorpha: Kermesidae). Newly acquired symbionts? Arthropod Struct. Dev. 2018, 47, 56–63. [Google Scholar] [CrossRef]
- De Jesus Mendez-Gallegos, S.; Tiberi, R.; Panzavolta, T. Carmine cochineal Dactylopius coccus Costa (Rhyncota: Dactylopiidae): Significance, production and use. Adv. Hortic. Sci. 2003, 2003, 1000–1007. [Google Scholar]
- Bustamante-Brito, R.; Vera-Ponce de León, A.; Rosenblueth, M.; Martínez-Romero, J.C.; Martínez-Romero, E. Metatranscriptomic analysis of the bacterial symbiont Dactylopiibacterium carminicum from the carmine cochineal Dactylopius coccus (Hemiptera: Coccoidea: Dactylopiidae). Life 2019, 9, 4. [Google Scholar] [CrossRef]
- Ramírez-Puebla, S.T.; Servín-Garcidueñas, L.E.; Ormeño-Orrillo, E.; de León, A.V.P.; Rosenblueth, M.; Delaye, L.; Martínez, J.; Martínez-Romero, E. Species in Wolbachia? Proposal for the designation of ‘Candidatus Wolbachia bourtzisii’, ‘Candidatus Wolbachia onchocercicola’, ‘Candidatus Wolbachia blaxteri’, ‘Candidatus Wolbachia brugii’, ‘Candidatus Wolbachia taylori’, ‘Candidatus Wolbachia collembolicola’ and ‘Candidatus Wolbachia multihospitum’ for the different species within Wolbachia supergroups. Syst. Appl. Microbiol. 2015, 38, 390–399. [Google Scholar]
- León, A.V.-P.; Dominguez-Mirazo, M.; Bustamante-Brito, R.; Higareda-Alvear, V.; Rosenblueth, M.; Martínez-Romero, E. Functional genomics of a Spiroplasma associated with the carmine cochineal Dactylopius coccus and Dactylopius opuntiae. BMC Genom. 2021, 22, 240. [Google Scholar]
- Vera-Ponce De León, A.; Sanchez-Flores, A.; Rosenblueth, M.; Martinez-Romero, E. Fungal community associated with Dactylopius (Hemiptera: Coccoidea: Dactylopiidae) and its role in uric acid metabolism. Front. Microbiol. 2016, 7, 954. [Google Scholar] [CrossRef] [PubMed]
- Menezes, C.; Vollet-Neto, A.; Marsaioli, A.J.; Zampieri, D.; Fontoura, I.C.; Luchessi, A.D.; Imperatriz-Fonseca, V.L. A Brazilian social bee must cultivate fungus to survive. Curr. Biol. 2015, 25, 2851–2855. [Google Scholar] [CrossRef] [PubMed]
- Vojvodic, S.; McCreadie, J.W. Do different species of Smittium (Harpellales, Legeriomycetaceae) influence each other in the host gut? Mycol. Res. 2008, 112, 1409–1413. [Google Scholar] [CrossRef] [PubMed]
- Bezerra, J.D.P.; Santos, M.G.S.; Svedese, V.M.; Lima, D.M.M.; Fernandes, M.J.S.; Paiva, L.M.; Souza-Motta, C.M. Richness of endophytic fungi isolated from Opuntia ficus-indica Mill. (Cactaceae) and preliminary screening for enzyme production. World J. Microbiol. Biotechnol. 2012, 28, 1989–1995. [Google Scholar] [CrossRef]
- Nygaard, S.; Hu, H.; Li, C.; Schiøtt, M.; Chen, Z.; Yang, Z.; Xie, Q.; Ma, C.; Deng, Y.; Dikow, R.B.; et al. Reciprocal genomic evolution in the ant–fungus agricultural symbiosis. Nat. Commun. 2016, 7, 12233. [Google Scholar] [CrossRef]
- Martens, E.C.; Lowe, E.C.; Chiang, H.; Pudlo, N.A.; Wu, M.; McNulty, N.P.; Abbott, D.W.; Henrissat, B.; Gilbert, H.J.; Bolam, D.N.; et al. Recognition and degradation of plant cell wall polysaccharides by two human gut symbionts. PLoS Biol. 2011, 9, e1001221. [Google Scholar] [CrossRef]
- Vega, F.E.; Dowd, P.F. The role of yeasts as insect endosymbionts. In Insect-Fungal Associations Ecology and Evolution; Vega, F.E., Blackwell, M., Eds.; Online edn; Oxford Academic: New York, NY, USA, 2005. [Google Scholar] [CrossRef]
- Leck, A. Preparation of lactophenol cotton blue slide mounts. Community Eye Health 1998, 12, 24. Available online: https://www.ncbi.nlm.nih.gov/pmc/articles/PMC1706009/ (accessed on 22 November 2019).
- Hageage, G.J.; Harrington, B.J. Use of Calcofluor White in clinical Mycology. Lab. Med. 1984, 15, 109–112. [Google Scholar] [CrossRef]
- Dugan, F.M. Illustrated Glossary of Fungal Structures; The American Phytopathological Society eBooks: St. Paul, MN, USA, 2017. [Google Scholar] [CrossRef]
- Hernández-Oaxaca, D.; Claro-Mendoza, K.L.; Rogel, M.A.; Rosenblueth, M.; Velasco-Trejo, J.A.; Alarcón-Gutiérrez, E.; García-Pérez, J.A.; Martínez-Romero, J.; James, E.K.; Martínez-Romero, E. Genomic diversity of Bradyrhizobium from the tree legumes Inga and Lysiloma (Caesalpinioideae-Mimosoid Clade). Diversity 2022, 14, 518. [Google Scholar] [CrossRef]
- Mishra, R.K.; Pandey, B.K.; Pathak, N.; Zeeshan, M. BOX-PCR-and ERIC-PCR-based genotyping and phylogenetic correlation among Fusarium oxysporum isolates associated with wilt disease in Psidium guajava L. Biocatal. Agric. Biotechnol. 2015, 4, 25–32. [Google Scholar] [CrossRef]
- Boyce, K.J.; Andrianopoulos, A. Fungal dimorphism: The switch from hyphae to yeast is a specialized morphogenetic adaptation allowing colonization of a host. FEMS Microbiol. Rev. 2015, 39, 797–811. [Google Scholar] [CrossRef]
- Douglas, A.E. Insects and Their Beneficial Microbes; Princeton University Press: Princeton, NJ, USA, 2022. [Google Scholar]
- Kobayashi, C.; Fukasawa, Y.; Hirose, D.; Kato, M. Contribution of symbiotic mycangial fungi to larval nutrition of a leaf-rolling weevil. Evol. Ecol. 2008, 22, 711–722. [Google Scholar] [CrossRef]
- Garrido, E.; Visel, A.; Tringe, S.G.; Partida-Martínez, L.P. The cacti microbiome: Interplay between habitat-filtering and host-specificity. Front. Microbiol. 2016, 7, 150. [Google Scholar] [CrossRef]
- Bateman, C.; Šigut, M.; Skelton, J.; Smith, K.E.; Hulcr, J. Fungal associates of the Xylosandrus compactus (Coleoptera: Curculionidae, Scolytinae) are spatially segregated on the insect body. Environ. Entomol. 2016, 45, 883–890. [Google Scholar] [CrossRef] [PubMed]
- Wang, Y.; Barth, D.; Tamminen, A.; Wiebe, M.G. Growth of marine fungi on polymeric substrates. BMC Biotechnol. 2016, 16, 1–3. [Google Scholar] [CrossRef]
- Stefanini, I. Yeast-insect associations: It takes guts. Yeast 2018, 35, 315–330. [Google Scholar] [CrossRef] [PubMed]
- Stefani, F.O.; Klimaszewski, J.; Morency, M.-J.; Bourdon, C.; Labrie, P.; Blais, M.; Venier, L.; Séguin, A. Fungal community composition in the gut of rove beetles (Coleoptera: Staphylinidae) from the Canadian boreal forest reveals possible endosymbiotic interactions for dietary needs. Fungal Ecol. 2016, 23, 164–171. [Google Scholar] [CrossRef]
- Salem, H.; Kirsch, R.; Pauchet, Y.; Berasategui, A.; Fukumori, K.; Moriyama, M.; Cripps, M.; Windsor, D.; Fukatsu, T.; Gerardo, N.M. Symbiont digestive range reflects host plant breadth in herbivorous beetles. Curr. Biol. 2020, 30, 2875–2886.e4. [Google Scholar] [CrossRef] [PubMed]
- Martínez-Romero, E.; Aguirre-Noyola, J.L.; Bustamante-Brito, R.; González-Román, P.; Hernández-Oaxaca, D.; Higareda-Alvear, V.; Montes-Carreto, L.M.; Martínez-Romero, J.C.; Rosenblueth, M.; Servín-Garcidueñas, L.E. We and herbivores eat endophytes. Microb. Biotechnol. 2021, 14, 1282–1299. [Google Scholar] [CrossRef]
- Varga, J.; Rigó, K.; Tóth, B.; Téren, J.; Kozakiewicz, Z. Evolutionary relationships among Aspergillus species producing economically important mycotoxins. Food Technol. Biotechnol. 2003, 41, 29–36. [Google Scholar]
- Barcoto, M.O.; Rodrigues, A. Lessons from insect fungiculture: From microbial ecology to plastics degradation. Front. Microbiol. 2022, 13, 812143. [Google Scholar] [CrossRef]
- Suen, G.; Scott, J.J.; Aylward, F.O.; Adams, S.M.; Tringe, S.G.; Pinto-Tomás, A.A.; Foster, C.E.; Pauly, M.; Weimer, P.J.; Barry, K.W.; et al. An insect herbivore microbiome with high plant biomass-degrading capacity. PLoS Genet. 2010, 6, e1001129. [Google Scholar] [CrossRef] [PubMed]
- Tamariz-Angeles, C.; Olivera-Gonzales, P.; Santillán-Torres, M.; Briceño-Luna, V.; Silva-Villafana, A.; Villena, G.K. Diverse biological activities and secondary metabolites profile of Penicillium brevicompactum HE19ct isolated from the high-Andean medicinal plant Perezia coerulescens. Fungal Biol. 2023, 127, 1439–1450. [Google Scholar] [CrossRef] [PubMed]
- Wang, D.; Huang, Z.; Billen, J.; Zhang, G.; He, H.; Wei, C. Structural diversity of symbionts and related cellular mechanisms underlying vertical symbiont transmission in cicadas. Env. Microbiol. 2021, 23, 6603–6621. [Google Scholar] [CrossRef] [PubMed]
- Wu, Y.H.; Xiao, G.K.; Chen, G.D.; Wang, C.X.; Hu, D.; Lian, Y.Y.; Lin, F.; Guo, L.D.; Yao, X.S.; Gao, H. Pericocins A–D, new bioactive compounds from Periconia sp. Nat. Prod. Commun. 2015, 10, 2127–2130. [Google Scholar] [CrossRef] [PubMed]
- Mora, M.A.E.; Castilho, A.M.C.; Fraga, M.E. Classification and infection mechanism of entomopathogenic fungi. Arq. Do Inst. Biológico 2017, 84, e0552015. [Google Scholar] [CrossRef]
- Vega, F.E.; Mercadier, G.; Dowd, P.F. Fungi Associated with the Coffee Berry Borer Hypothenemus hampei (Ferrari) (Coleoptera: Scolytidae); Colloque Scientifique International Sur Le Café: Lausanne, Switzerland, 1999; Volume 18, pp. 229–238. [Google Scholar]
- Simon, J.-C.; Marchesi, J.R.; Mougel, C.; Selosse, M.-A. Host-microbiota interactions: From holobiont theory to analysis. Microbiome 2019, 7, 5. [Google Scholar] [CrossRef]
- Bustamante-Brito, R.; Vera-Ponce de León, A.; Rosenblueth, M.; Martínez-Romero, E. Comparative genomics of the carmine cochineal symbiont Candidatus Dactylopiibacterium carminicum reveals possible protection to the host against viruses via CRISPR/Cas. Syst. Appl. Microbiol. 2024, 47, 126540. [Google Scholar] [CrossRef]
- Huang, Y.T.; Skelton, J.; Hulcr, J. Lipids and small metabolites provisioned by ambrosia fungi to symbiotic beetles are phylogeny-dependent, not convergent. ISME J. 2020, 14, 1089–1099. [Google Scholar] [CrossRef]
- Paludo, C.R.; Menezes, C.; Silva-Junior, E.A.; Vollet-Neto, A.; Andrade-Dominguez, A.; Pishchany, G.; Khadempour, L.; Nascimento, F.S.D.; Currie, C.R.; Kolter, R.; et al. Stingless bee larvae require fungal steroids to pupate. Sci. Rep. 2018, 8, 1122. [Google Scholar] [CrossRef] [PubMed]
Disclaimer/Publisher’s Note: The statements, opinions and data contained in all publications are solely those of the individual author(s) and contributor(s) and not of MDPI and/or the editor(s). MDPI and/or the editor(s) disclaim responsibility for any injury to people or property resulting from any ideas, methods, instructions or products referred to in the content. |
© 2024 by the authors. Licensee MDPI, Basel, Switzerland. This article is an open access article distributed under the terms and conditions of the Creative Commons Attribution (CC BY) license (https://creativecommons.org/licenses/by/4.0/).